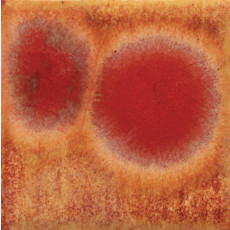
Dragons Breath Mayco Jungle Gem Dragons Breath Mayco Jungle Gem

TerraColor Lime Gloss Earthenware Brush On Glaze FE5030
Description
Terracolor Brush-On Earthenware Glazes are available ready to use straight from the jar, simply stir well then apply three coats to your bisque pieces. Glaze will dry quickly allowing you to move them to the kiln for firing. For best results fire 1040°C with a 30 minute soak on a computerised controller.
Firing range: 1020°C - 1080°C
Finish: Shiny
Acid Resistance: Contains cadmium frit
Dishwasher Resistance: Good
Leadless
230ml jars

Share
TerraColor Lime Gloss Earthenware Brush On Glaze FE5030
Facebook Twitter Email Pinterest Telegram